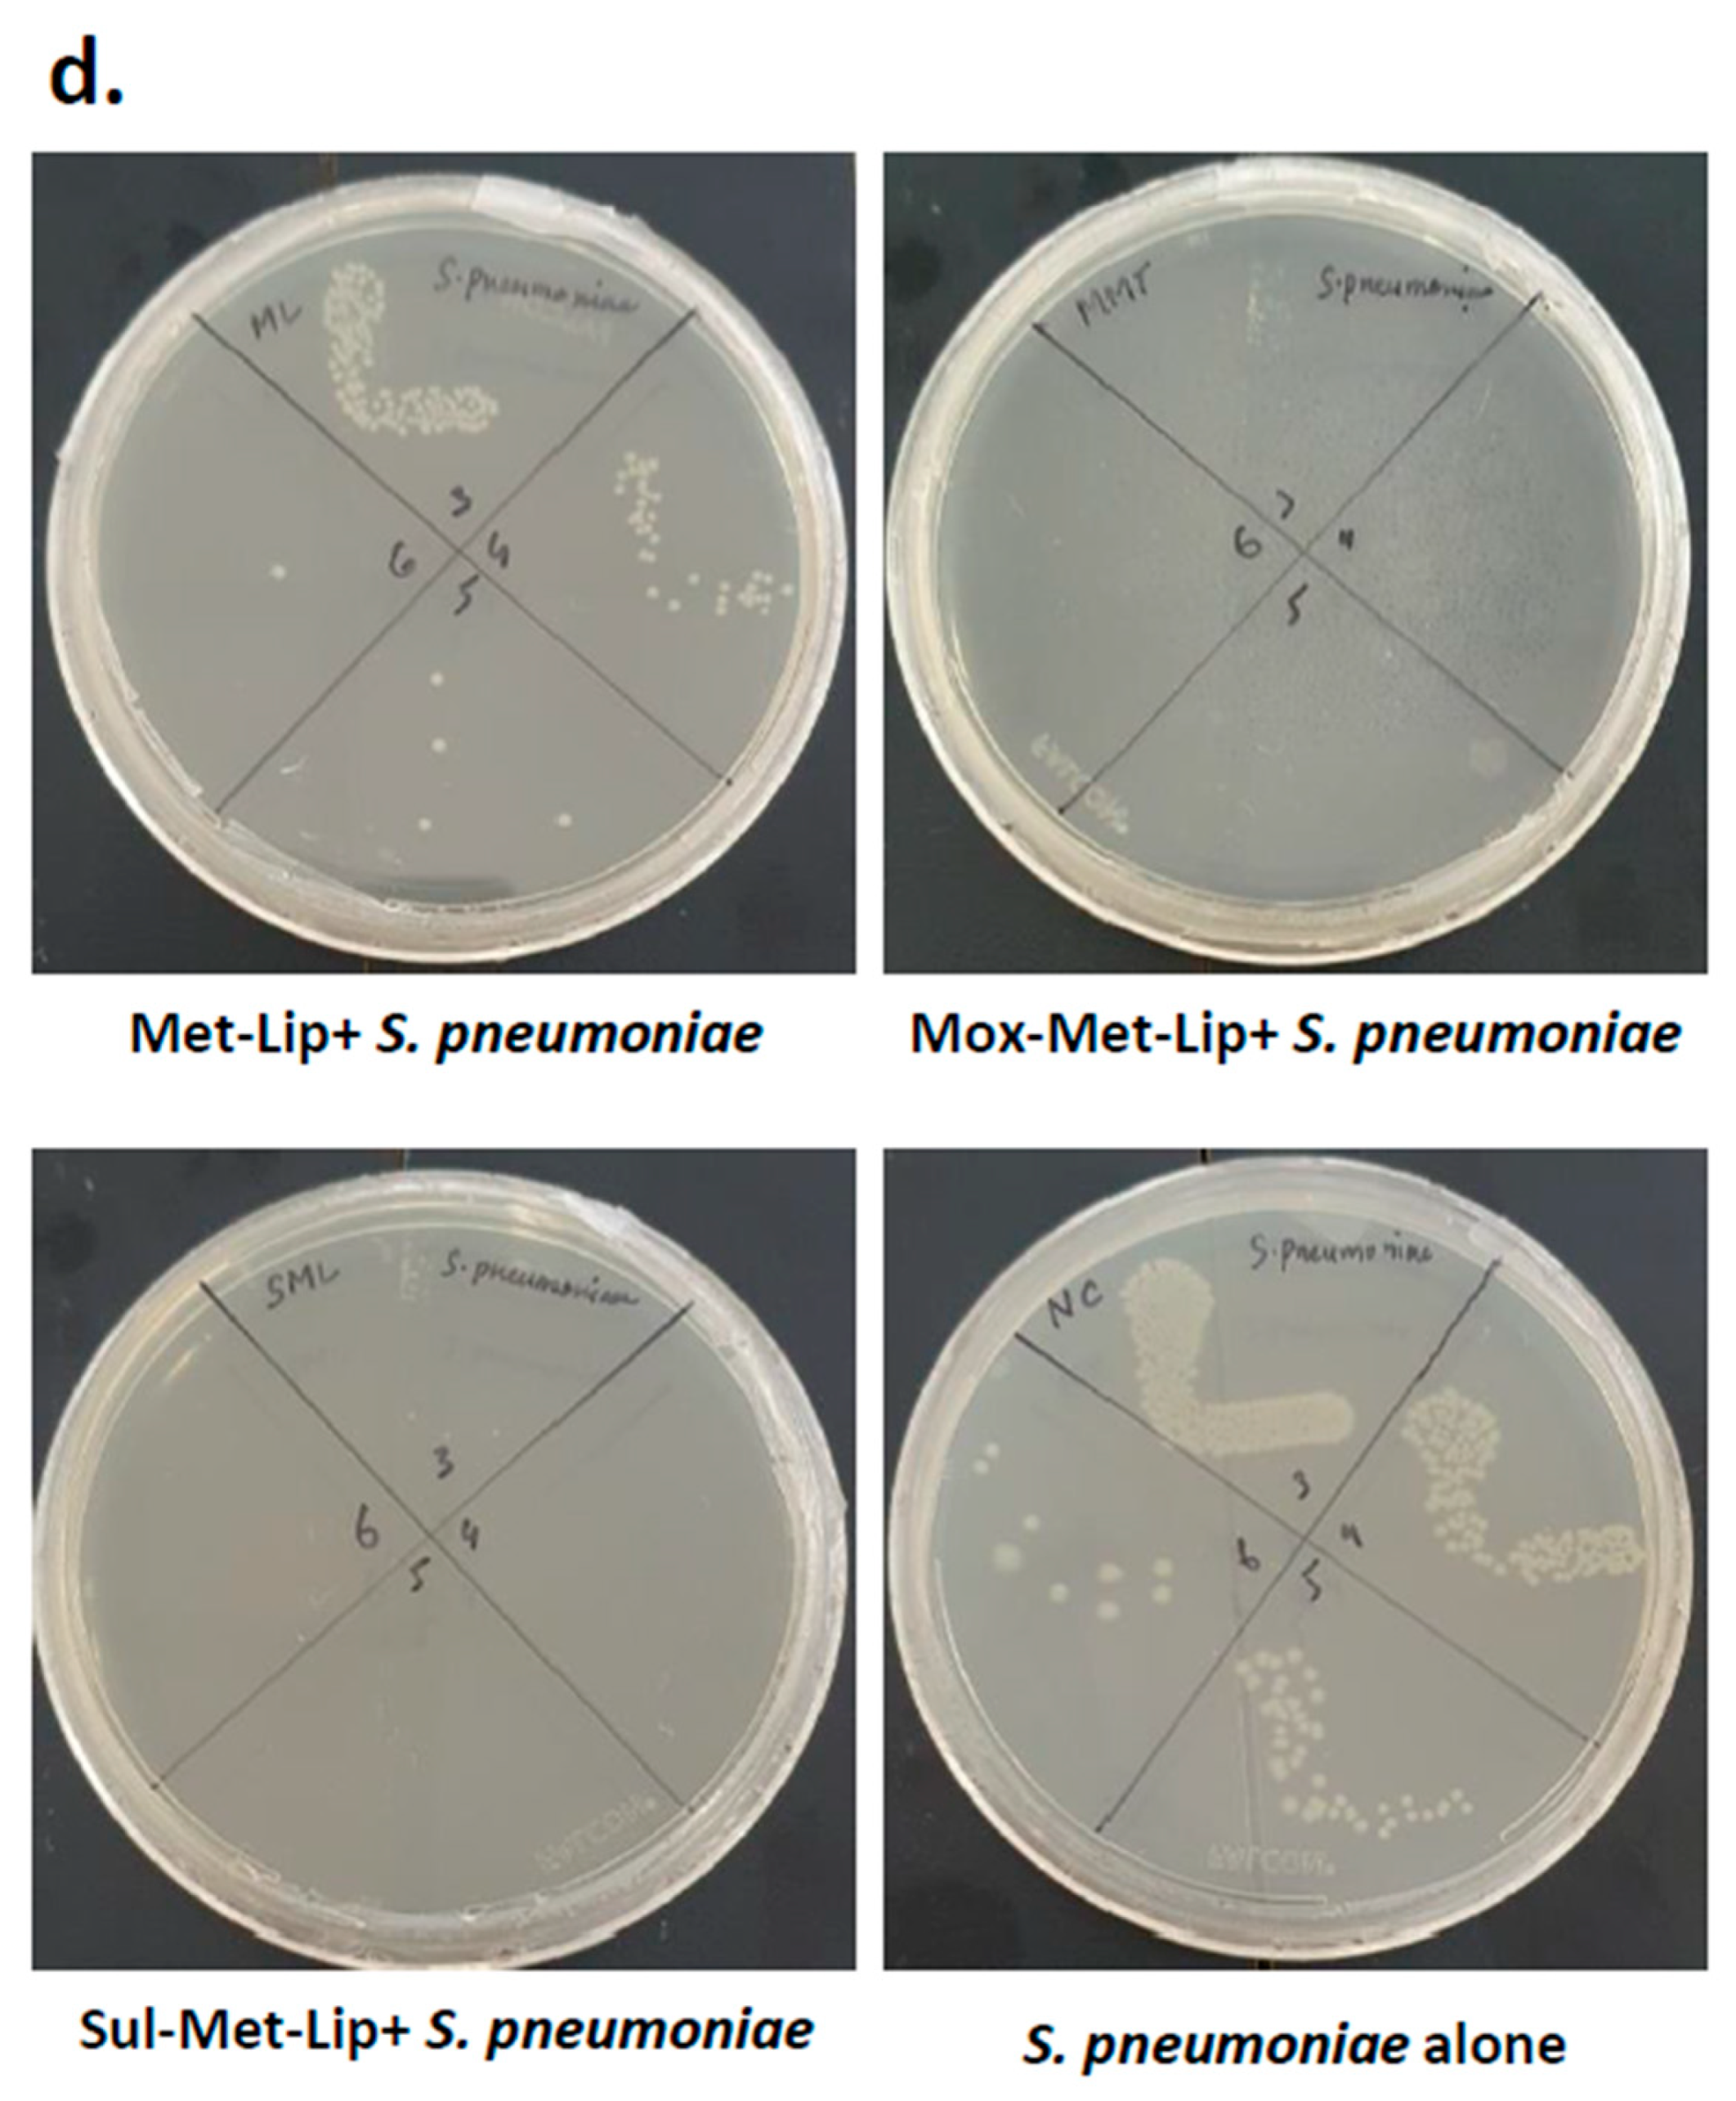

Moxifloxacin and Sulfamethoxazole-Based Nanocarriers Exhibit Potent Antibacterial Activities
Abstract
1. Introduction
2. Materials and Methods
2.1. Synthesis of 2-(2-Methyl-5-nitro-1H-imidazol-1-yl)ethyldecanoate (DC-Met-10)
2.2. Zeta Potential, Size, Polydispersity Index, and Surface Morphology
2.3. Efficiency of Drug Entrapment
2.4. FTIR Spectroscopy
2.5. Hemolysis Assay
2.6. Bacterial Cultures Used in this Study
2.7. Antibacterial Assays
2.8. In Vitro Host Cell Cytotoxicity
2.9. Statistical Asessment
3. Results
3.1. Synthesis of DC-Met-10
3.2. Particle Size, PDI, Zeta Potential, and Surface Morphology
3.3. % Encapsulation Efficiency of Drug-Loaded Niosomes
3.4. FTIR Spectroscopy
3.5. Biocompatibility Studies
3.6. Moxifloxacin- and Sulfamethoxazole-Loaded Nanocarrier Presented Potent Antibacterial Efficacy against MDR Bacteria
3.7. Moxifloxacin- and Sulfamethoxazole-Loaded Nanocarriers Presented Negligible Cytotoxicity
4. Discussion
5. Conclusions
Author Contributions
Funding
Data Availability Statement
Conflicts of Interest
References
- Li, B.; Webster, T.J. Bacteria antibiotic resistance: New challenges and opportunities for implant-associated or-thopedic infections. J. Orthop. Res. 2018, 36, 22–32. [Google Scholar] [CrossRef]
- Khameneh, B.; Diab, R.; Ghazvini, K.; Bazzaz, B.S.F. Breakthroughs in bacterial resistance mechanisms and the potential ways to combat them. Microb. Pathog. 2016, 95, 32–42. [Google Scholar] [CrossRef] [PubMed]
- Munita, J.M.; Arias, C.A. Mechanisms of antibiotic resistance. Microbiol. Spectr. 2016, 4, 481–511. [Google Scholar] [CrossRef]
- Nathan, C.; Cars, O. Antibiotic Resistance—Problems, Progress, and Prospects. N. Engl. J. Med. 2014, 371, 1761–1763. [Google Scholar] [CrossRef]
- Masri, A.; Anwar, A.; Khan, N.A.; Siddiqui, R. The Use of Nanomedicine for Targeted Therapy against Bacterial Infections. Antibiotics 2019, 8, 260. [Google Scholar] [CrossRef]
- Agarwal, H.; Menon, S.; Kumar, S.V.; RajeshKumar, S. Mechanistic study on antibacterial action of zinc oxide nanoparticles synthesized using green route. Chem. Interact. 2018, 286, 60–70. [Google Scholar] [CrossRef] [PubMed]
- Anwar, A.; Masri, A.; Rao, K.; Rajendran, K.; Khan, N.; Shah, M.R.; Siddiqui, R. Antimicrobial activities of green synthesized gums-stabilized nanoparticles loaded with flavonoids. Sci. Rep. 2019, 9, 3122. [Google Scholar] [CrossRef]
- Erjaee, H.; Rajaian, H.; Nazifi, S. Synthesis and characterization of novel silver nanoparticles using Chamaemelumnobile extract for antibacterial application. Adv. Nat. Sci. Nanosci. Nanotechnol. 2017, 8, 025004. [Google Scholar] [CrossRef]
- Li, M.; Jiang, X.; Wang, D.; Xu, Z.; Yang, M. In situ reduction of silver nanoparticles in the lignin based hydrogel for enhanced antibacterial application. Colloids Surf. B Biointerfaces 2019, 177, 370–376. [Google Scholar] [CrossRef]
- Yin, I.X.; Zhang, J.; Zhao, I.S.; Mei, M.L.; Li, Q.; Chu, C.H. The Antibacterial Mechanism of Silver Nanoparticles and Its Application in Dentistry. Int. J. Nanomed. 2020, 15, 2555–2562. [Google Scholar] [CrossRef]
- Kesharwani, P.; Gorain, B.; Low, S.Y.; Tan, S.A.; Ling, E.C.S.; Lim, Y.K.; Chin, C.M.; Lee, P.Y.; Lee, C.M.; Ooi, C.H.; et al. Nanotechnology based approaches for anti-diabetic drugs delivery. Diabetes Res. Clin. Pract. 2018, 136, 52–77. [Google Scholar] [CrossRef]
- Leonida, M.D.; Kumar, I. Nanoparticles, Nanomaterials and Nanocarriers. In Bionanomaterials for Skin Regeneration; Springer: Cham, Switzerland, 2016; pp. 37–46. [Google Scholar]
- Mura, S.; Nicolas, J.; Couvreur, P. Stimuli-responsive nanocarriers for drug delivery. Nat. Mater. 2013, 12, 991–1003. [Google Scholar] [CrossRef]
- Neubert, R.H. Potentials of new nanocarriers for dermal and transdermal drug delivery. Eur. J. Pharm. Biopharm. 2011, 77, 1–2. [Google Scholar] [CrossRef]
- Masri, A.; Anwar, A.; Ahmed, D.; Siddiqui, R.B.; Raza Shah, M.; Khan, N.A. Silver nanoparticle conjuga-tion-enhanced antibacterial efficacy of clinically approved drugs cephradine and vildagliptin. Antibiotics 2018, 7, 100. [Google Scholar] [CrossRef]
- Balfour, J.A.B.; Lamb, H.M. Moxifloxacin. Drugs 2000, 59, 115–139. [Google Scholar] [CrossRef]
- Szabó, Z.I.; Deme, R.; Mucsi, Z.; Rusu, A.; Mare, A.D.; Fiser, B.; Toma, F.; Sipos, E.; Tóth, G. Equilibrium, structural and antibacterial characterization of moxifloxacin-β-cyclodextrin complex. J. Mol. Struct. 2018, 1166, 228–236. [Google Scholar] [CrossRef]
- Masters, P.A.; O’Bryan, T.A.; Zurlo, J.; Miller, D.Q.; Joshi, N. Trimethoprim-Sulfamethoxazole Revisited. Arch. Intern. Med. 2003, 163, 402–410. [Google Scholar] [CrossRef] [PubMed]
- Ai, X.; Zhong, L.; Niu, H.; He, Z. Thin-film hydration preparation method and stability test of DOX-loaded di-sulfide-linked polyethylene glycol 5000-lysine-di-tocopherol succinate nanomicelles. Asian J. Pharm. Sci. 2014, 9, 244–250. [Google Scholar] [CrossRef]
- Anwar, A.; Rajendran, K.; Siddiqui, R.; Shah, M.R.; Khan, N.A. Clinically Approved Drugs against CNS Diseases as Potential Therapeutic Agents To Target Brain-Eating Amoebae. ACS Chem. Neurosci. 2018, 10, 658–666. [Google Scholar] [CrossRef]
- Tsamesidis, I.; Pouroutzidou, G.K.; Lymperaki, E.; Kazeli, K.; Lioutas, C.B.; Christodoulou, E.; Perio, P.; Reybier, K.; Pantaleo, A.; Kontonasaki, E. Effect of ion doping in silica-based nanoparticles on the hemolytic and oxidative activity in contact with human erythrocytes. Chem. Interact. 2020, 318, 108974. [Google Scholar] [CrossRef] [PubMed]
- Akbar, N.; Khan, N.A.; Sagathevan, K.; Iqbal, M.; Tawab, A.; Siddiqui, R. Gut bacteria of Cuora amboinensis (turtle) produce broad-spectrum antibacterial molecules. Sci. Rep. 2019, 9, 1–19. [Google Scholar] [CrossRef]
- Akbar, N.; Siddiqui, R.; Iqbal, M.; Sagathevan, K.; Kim, K.S.; Habib, F.; Khan, N.A. Gut Bacteria of Rattus rattus (Rat) Produce Broad-Spectrum Antibacterial Lipopeptides. ACS Omega 2021, 6, 12261–12273. [Google Scholar] [CrossRef] [PubMed]
- Griffin, B.T.; Guo, J.; Presas, E.; Donovan, M.D.; Alonso, M.J.; O’Driscoll, C.M. Pharmacokinetic, pharmacody-namic and biodistribution following oral administration of nanocarriers containing peptide and protein drugs. Adv. Drug Deliv. Rev. 2016, 106, 367–380. [Google Scholar] [CrossRef] [PubMed]
- Kaskoos, R. Investigation of moxifloxacin loaded chitosan-dextran nanoparticles for topical instillation into eye: In-vitro and ex-vivo evaluation. Int. J. Pharm. Investig. 2014, 4, 164–173. [Google Scholar] [CrossRef]
- Sohrabi, S.; Haeri, A.; Mahboubi, A.; Mortazavi, A.; Dadashzadeh, S. Chitosan gel-embedded moxifloxacin niosomes: An efficient antimicrobial hybrid system for burn infection. Int. J. Biol. Macromol. 2016, 85, 625–633. [Google Scholar] [CrossRef]
- Imran, M.; Shah, M.R.; Ullah, F.; Ullah, S.; Sadiq, A.; Ali, I.; Ahmed, F.; Nawaz, W. Double-tailed acyl glycoside niosomal nanocarrier for enhanced oral bioavailability of Cefixime. Artif. Cells Nanomed. Biotechnol. 2016, 45, 1440–1451. [Google Scholar] [CrossRef]
- Tavano, L.; Aiello, R.; Ioele, G.; Picci, N.; Muzzalupo, R. Niosomes from glucuronic acid-based surfactant as new carriers for cancer therapy: Preparation, characterization and biological properties. Colloids Surf. B Biointerfaces 2014, 118, 7–13. [Google Scholar] [CrossRef] [PubMed]
- Alemi, A.; Reza, J.Z.; Haghiralsadat, F.; Jaliani, H.Z.; Karamallah, M.H.; Hosseini, S.A.; Karamallah, S.H. Paclitaxel and curcumin coadministration in novel cationic PEGylated niosomal formulations exhibit enhanced synergistic antitumor efficacy. J. Nanobiotechnol. 2018, 16, 28. [Google Scholar] [CrossRef]
- Chen, D.-Z.; Tang, Q.; Li, X.; Zhou, X.; Zang, J.; Xiang, J.-Y.; Guo, C.-Q.; Xue, W.-Q. Biocompatibility of magnetic Fe3O4 nanoparticles and their cytotoxic effect on MCF-7 cells. Int. J. Nanomed. 2012, 7, 4973–4982. [Google Scholar] [CrossRef]
- Siddiqui, R.; Khan, N.A. Infection control strategy by killing drug-resistant bacteria. Pathog. Glob. Heal. 2013, 107, 215–216. [Google Scholar] [CrossRef][Green Version]
- Peraman, R.; Sure, S.K.; Dusthackeer, V.A.; Chilamakuru, N.B.; Yiragamreddy, P.R.; Pokuri, C.; Kutagulla, V.K.; Chinni, S. Insights on recent approaches in drug discovery strategies and untapped drug targets against drug re-sistance. Future J. Pharm. Sci. 2021, 7, 1–25. [Google Scholar]
- World Health Organization (WHO). New Report Calls for Urgent Action to Avert Antimicrobial Resistance Crisis; WHO: Geneva, Swizerland, 2019; Available online: https://www.who.int/news-room/detail/29-04-2019-new-report-calls-for-urgent-action-to-avert-antimicrobial-resistance-crisis (accessed on 9 June 2021).
- Singh, R.; Smitha, M.S.; Singh, S.P. The Role of Nanotechnology in Combating Multi-Drug Resistant Bacteria. J. Nanosci. Nanotechnol. 2014, 14, 4745–4756. [Google Scholar] [CrossRef]
- Din, F.U.; Aman, W.; Ullah, I.; Qureshi, O.S.; Mustapha, O.; Shafique, S.; Zeb, A. Effective use of nanocarriers as drug delivery systems for the treatment of selected tumors. Int. J. Nanomed. 2017, 12, 7291–7309. [Google Scholar] [CrossRef]
- Chamundeeswari, M.; Sobhana, S.S.L.; Jacob, J.; Kumar, M.G.; Devi, M.P.; Sastry, T.P.; Mandal, A.B. Preparation, characterization and evaluation of a biopolymeric gold nanocomposite with antimicrobial activity. Biotechnol. Appl. Biochem. 2010, 55, 29–35. [Google Scholar] [CrossRef]
- Dong, A.; Lan, S.; Huang, J.; Wang, T.; Zhao, T.; Xiao, L.; Wang, W.; Zheng, X.; Liu, F.; Gao, G.; et al. Modifying Fe3O4-Functionalized Nanoparticles with N-Halamine and Their Magnetic/Antibacterial Properties. ACS Appl. Mater. Interfaces 2011, 3, 4228–4235. [Google Scholar] [CrossRef]
- Fang, J.; Lyon, D.; Wiesner, M.R.; Dong, A.J.; Alvarez, P. Effect of a Fullerene Water Suspension on Bacterial Phospholipids and Membrane Phase Behavior. Environ. Sci. Technol. 2007, 41, 2636–2642. [Google Scholar] [CrossRef]
- Hajipour, M.J.; Fromm, K.M.; Ashkarran, A.A.; de Aberasturi, D.J.; de Larramendi, I.R.; Rojo, T.; Serpooshan, V.; Parak, W.J.; Mahmoudi, M. Antibacterial properties of nanoparticles. Trends Biotechnol. 2012, 30, 499–511. [Google Scholar] [CrossRef] [PubMed]
- Mukheem, A.; Muthoosamy, K.; Manickam, S.; Sudesh, K.; Shahabuddin, S.; Saidur, R.; Akbar, N.; Sridewi, N. Fabrication and characterization of an electrospun PHA/graphene silver nanocomposite scaffold for antibacterial appli-cations. Materials 2018, 11, 1673. [Google Scholar] [CrossRef] [PubMed]
- Mukheem, A.; Shahabuddin, S.; Akbar, N.; Miskon, A.; Sarih, N.M.; Sudesh, K.; Khan, N.A.; Saidur, R.; Sridewi, N. Boron Nitride Doped Polyhydroxyalkanoate/Chitosan Nanocomposite for Antibacterial and Biological Applications. Nanomaterials 2019, 9, 645. [Google Scholar] [CrossRef] [PubMed]
- Uğur, Ş.S.; Sarıışık, M.; Aktaş, A.H.; Uçar, M.Ç.; Erden, E. Modifying of cotton fabric surface with nano-ZnO multilayer films by layer-by-layer deposition method. Nanoscale Res. Lett. 2010, 5, 1204–1210. [Google Scholar] [CrossRef]
- Shah, A.; Yameen, M.A.; Fatima, N.; Murtaza, G. Chemical synthesis of chitosan/silver nanocomposites films loaded with moxifloxacin: Their characterization and potential antibacterial activity. Int. J. Pharm. 2019, 561, 19–34. [Google Scholar] [CrossRef] [PubMed]
- Ahmed, S.; Saifullah; Ahmad, M.; Swami, B.L.; Ikram, S. Green synthesis of silver nanoparticles using Azadirachta indica aqueous leaf extract. J. Radiat. Res. Appl. 2016, 9, 1–7. [Google Scholar] [CrossRef]
- Shah, A.; Ashames, A.A.; Buabeid, M.A.; Murtaza, G. Synthesis, in vitro characterization and antibacterial efficacy of moxifloxacin-loaded chitosan-pullulan-silver-nanocomposite films. J. Drug Deliv. Sci. Technol. 2020, 55, 101366. [Google Scholar] [CrossRef]
- Mehrabi, F.; Shamspur, T.; Mostafavi, A.; Hakimi, H.; Mohamadi, M. Inclusion of sulfamethoxazole in a novel CuFe2O4 nanoparticles/mesoporous silica-based nanocomposite: Release kinetics and antibacterial activity. Appl. Organomet. Chem. 2020, 35, 6035. [Google Scholar] [CrossRef]
- Aseichev, A.V.; Azizova, O.A.; Beckman, E.M.; Skotnikova, O.I.; Dudnik, L.B.; Shcheglovitova, O.N.; Sergienko, V.I. Effects of Gold Nanoparticles on Erythrocyte Hemolysis. Bull. Exp. Biol. Med. 2014, 156, 495–498. [Google Scholar] [CrossRef] [PubMed]

| Bacterial Isolate | Strain |
|---|---|
| Streptococcus pyogenes | ATCC 49399 (clinical isolate) |
| Methicillin resistant Staphylococcus aureus | MTCC 381123 (clinical isolate) |
| Streptococcus pneumoniae | ATCC 13883 (clinical isolate) |
| Bacillus cereus | MTCC 131621 (clinical isolate) |
| Escherichia coli K1 | MTCC 710859 (clinical isolate) |
| Pseudomonas aeruginosa | ATCC 10145 (clinical isolate) |
| Klebsiella pneumonia | ATCC 13883 (clinical isolate) |
| Serratia marcescens | MTCC 13880 (clinical isolate) |
| Sample | Composition (Compound: Drug: Cholesterol) | Drug EE% | Average Vesicle Size (nm) | PDI | Zeta Potential (mV) |
|---|---|---|---|---|---|
| MOX-Met-Lip | 2:2:1 | 73.45 ± 2.27 | 184.7 ± 3.61 | 0.375 ± 0.03 | −10.1 ± 3.32 |
| SUL-Met-Lip | 2:2:1 | 90.35 ± 2.51 | 258.2 ± 5.64 | 0.308 ± 0.023 | −14.6 ± 2.25 |
| Met-Lip | 2:0:0 | 0.00 | 149.0 ± 4.45 | 0.213 ± 0.032 | −12.4 ± 2.5 |
| Concentration of Compounds (2000 µg/mL) | Hemolysis (%) |
|---|---|
| DC-Met-10 | |
| 10 | - |
| 50 | - |
| 100 | - |
| 250 | - |
| 500 | - |
| 750 | - |
| 1000 | - |
| 1250 | - |
| 1500 | 2.0% ± 0.06% |
| 1750 | 3.5% ± 0.1% |
| 2000 | 5.5% ± 0.2% |
Publisher’s Note: MDPI stays neutral with regard to jurisdictional claims in published maps and institutional affiliations. |
© 2021 by the authors. Licensee MDPI, Basel, Switzerland. This article is an open access article distributed under the terms and conditions of the Creative Commons Attribution (CC BY) license (https://creativecommons.org/licenses/by/4.0/).
Share and Cite
Akbar, N.; Gul, J.; Siddiqui, R.; Shah, M.R.; Khan, N.A. Moxifloxacin and Sulfamethoxazole-Based Nanocarriers Exhibit Potent Antibacterial Activities. Antibiotics 2021, 10, 964. https://doi.org/10.3390/antibiotics10080964
Akbar N, Gul J, Siddiqui R, Shah MR, Khan NA. Moxifloxacin and Sulfamethoxazole-Based Nanocarriers Exhibit Potent Antibacterial Activities. Antibiotics. 2021; 10(8):964. https://doi.org/10.3390/antibiotics10080964
Chicago/Turabian StyleAkbar, Noor, Jasra Gul, Ruqaiyyah Siddiqui, Muhammad Raza Shah, and Naveed Ahmed Khan. 2021. "Moxifloxacin and Sulfamethoxazole-Based Nanocarriers Exhibit Potent Antibacterial Activities" Antibiotics 10, no. 8: 964. https://doi.org/10.3390/antibiotics10080964
APA StyleAkbar, N., Gul, J., Siddiqui, R., Shah, M. R., & Khan, N. A. (2021). Moxifloxacin and Sulfamethoxazole-Based Nanocarriers Exhibit Potent Antibacterial Activities. Antibiotics, 10(8), 964. https://doi.org/10.3390/antibiotics10080964

